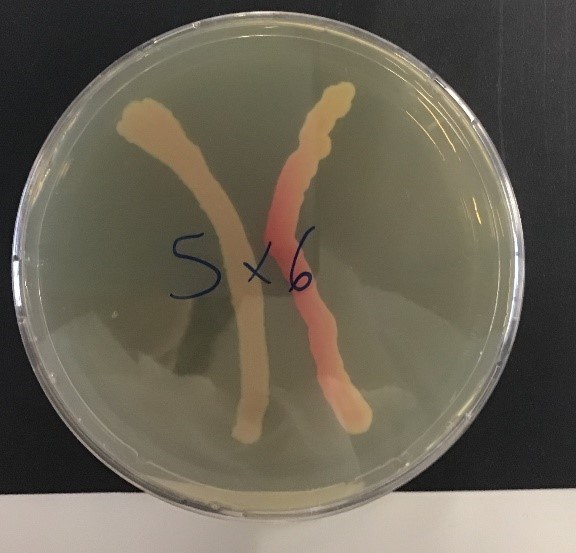

Summer Science Academy 2019
Zwei Wochen zwischen Bakteriophagen, Kunst und Pharmaindustrie

Zu Beginn der Sommerferien 2019 erhielten wir beide und 16 weitere Schüler/innen verschiedener Gymnasien die Möglichkeit, für zwei Wochen an einem in englischer Sprache gehaltenen Workshop des Biozentrums Basel teilzunehmen.
Das Thema der «Summer Science Academy 2019» lautete "Bakteriophagen", es ging also um Viren, die Bakterien befallen.
Dabei lernten wir zunächst einmal, wie man im Labor arbeiten muss, wie man pipettiert und wie man Proben richtig beschriftet.

Wir kamen in Genuss unterschiedlicher Referate aus den Fachbereichen Biologie und Wissenschaft.
So kam etwa Daniel Küry zu Besuch, mit dem wir am Rhein Wasserproben entnahmen und die Tiere, die wir darin fanden, bestimmten sowie unter dem Mikroskop betrachteten.
Auch standen Besuche in der «Novartis» und der «Idorsia» an. In beiden Konzernen erfuhren sehr viel Neues und bekamen einen interessanten Einblick in die Pharmaindustrie.
Prof. Dr. Alexander Schier, Leiter des Biozentrums, sprach über die Entwicklung von Zebrafischen, die wir währenddessen auch unter dem Mikroskop betrachten durften. Dabei erfuhren wir, wieso diese Fischart ein so beliebtes Forschungsobjekt ist. Ferner gab es weitere Vorträge und zwei Museumsbesuche. Wir bekamen den Auftrag, eine Wasserprobe von einem Ort unserer Wahl mitzubringen. Aus diesen Proben isolierten wir unsere Phagen zunächst aus dem Wasser. Anschliessend gaben wir diese in verschieden hohen Konzentrationen auf Agarplatten und Bakterien und liessen sie über Nacht «wachsen». Als Bakterium verwendeten wir immer den gleichen Bakterienstamm, das «Perfect Victim». Als unsere Phagen sogenannte «Plugs» gebildet hatten, isolierten wir sie von der Agar- und Bakterienplatte. Nebenbei testeten wir die Phagen wieder auf dem «Perfect Victim», dass jedoch dieses Mal über verschiedene Abwehrsysteme verfügte.
Die aus dem Agar (Bakterium) isolierten Phagen gaben wir erneut in verschiedenen Konzentrationen auf neue Agarplatten, die wir wiederum mit Bakterien versorgten.
So konnten wir feststellen, ob es sich wirklich um einen Phagen handelte (teilweise waren es nur Luftblasen). Wenn in einer Probe keine Phagen vorhanden waren, bekam man einen «Backup Phage» von den Tutoren. Die isolierten Phagen wurde von den Tutoren für das Elektronenmikroskop (TEM) vorbereitet.
Eine weitere interessante Arbeit, die wir machten, war das Cross-Feeding. Dabei untersuchten wir den Einfluss von zwei Bakterienstämmen aufeinander. Dies war möglich, da die verschiedenen Bakterienstämme unterschiedlich gefärbt waren.
So sah man, wie sie sich gegenseitig beeinflussten. Dieses Experiment führten wir mit der Hilfe von Dr. David Thaler, dem Kursdirektor, aus.

Am letzten Tag der «Summer Science School 2019» fand ein «interner» Abschluss statt. Fröhlich und entspannt liessen wir die Zeit bei der Buvette St. Louis am Rhein ausklingen.
Im September fand ein letzter Workshoptag statt. In der Zwischenzeit hatten die Tutoren die DNA unserer Phagen sequenziert. Die Ergebnisse, die herausgekommen sind, waren sehr interessant. Wir erfuhren, dass mehrere unserer Phagen untereinander verwandt waren. Auch erfuhren wir etwas über deren spezifische Eigenschaften. Wir wurden aber darauf aufmerksam gemacht, dass diese Phagen nur weit entfernt miteinander verwandt sind, was unter anderem daran liegt, dass es so viele unterschiedliche Phagen gibt.

Es gab auch einen kleinen Wettbewerb. Wir durften «Agarart» betreiben, d.h. mit fluoreszierenden Bakterien eine Agarplatte bemalen.
Die drei besten Kunstwerke wurden von den Tutoren erkoren.
Am 5. November fand der Abschlussabend statt. Dort wurden die Ergebnisse allen Interessierten präsentiert. Ebenso die Geschichten, die von uns Teilnehmenden geschrieben wurden. Denn am Anfang bekam jeder ein kleines Taschenmikroskop, das man an das Handy montieren konnte. Dazu folgte der Auftrag, ein Foto zu machen und eine Geschichte dazu zu schreiben. Ausserdem erhielten wir alle ein «Diplom», auf dem der Phage, den man entdeckt hatte, und der Name, den man ihm gegeben hatte, abgebildet ist.

Wir hatten sehr viel Spass in diesen zwei Wochen. Wir konnten sehr viel Interessantes dazulernen und möchten uns nochmals herzlich bei allen, die dieses Projekt ermöglicht haben, bedanken.
Den Film zur Basel Summer Science Academy 2019 finden Sie HIER.
Autorinnen: Aaliyah Fripp, 2A und Charlotte Löffler, 5F
